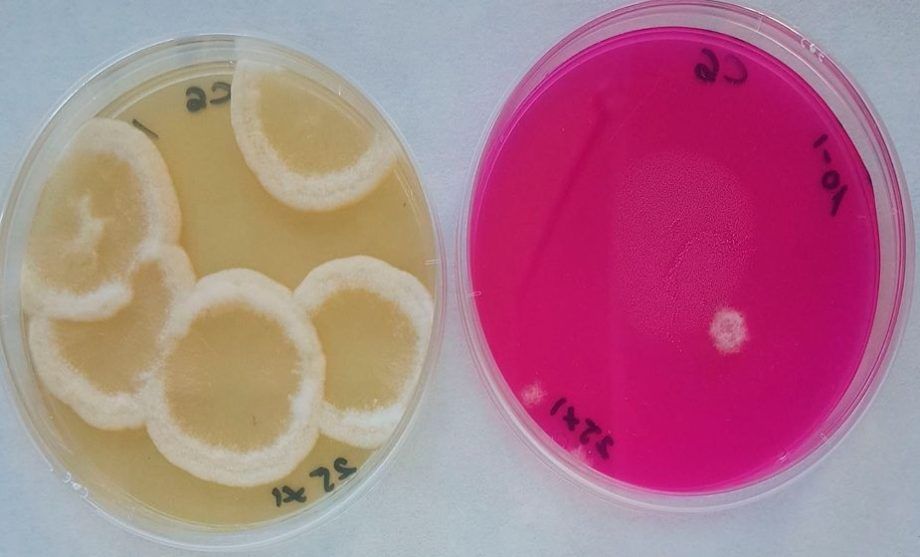

Durante el último verano – otoño desde la Asociación de Castañicultores de los tres valles en El Bierzo Oeste han mostrado su preocupación por la defoliación prematura del castaño en esta zona. El diagnóstico inicial realizado apuntaba a la socarrina (Septoria castaenicolum), un hongo autóctono de difícil control, en el que las condiciones ambientales adversas, caracterizadas por una humedad elevada que se produjo durante el mes de julio, y que provocó la pérdida de hoja de los sotos de castaño.
El efecto de esta enfermedad ha sido, además del debilitamiento general del castaño, la disminución de la cosecha de castaña. Por ello, ante la continua preocupación del sector productivo, desde la Mesa del Castaño del Bierzo se activó el programa de vigilancia fitosanitaria, que a través de Cesefor realizó actividades de prospección, análisis e identificación, sobre las muestras facilitadas por los socios de esta asociación con sede en el Bierzo Oeste y las recogidas en las parcelas de seguimiento.
Para su estudio se ha realizado un análisis en el laboratorio del Instituto de Biotecnología de León, Inbiotec, (en proceso de integración en Cesefor) y que mediante técnicas de análisis genético ha confirmado la presencia de Gnoniopsis smithogilvyi en casi un 80% de las muestras recibidas, entre otras patologías (no causantes de daños reseñables).
Para ello, y en el marco del proyecto +cast, financiado por el Instituto de Competitividad Empresarial de Castilla y León (ICE-JCyL) se diseñó y realizó un procedimiento experimental consistente en el aislamiento en medios selectivos de la biota presente en el tejido de las muestras y en la selección y resiembra de los microorganismos en cultivos puros. Posteriormente se extrajo el ADN y se secuenció identificándose el organismo indicado, entre otros patógenos de menor interés por su escaso impacto.
Gnoniopsis es un hongo que se había descrito tras la aparición de la avispilla en todas las regiones productoras europeas y se caracteriza por afectar internamente a la castaña, alterando su calidad organoléptica (propiedades relativas al sabor y al aroma).
En la actualidad se están evaluando posibles soluciones a esta afección del castaño y la castaña, realizándose en este laboratorio gestionado por Cesefor investigaciones encaminadas a determinar estrategias y medios de control, y así poder realizar desde la Mesa del castaño del Bierzo las consiguientes recomendaciones de gestión al sector, que principalmente consisten en una gestión rápida de la recogida del fruto y tratamiento térmico posterior del mismo, antes de su envío a los mercados.
Desde Cesefor se espera que la entrada en funcionamiento de este servicio de detección temprana de patologías en el ámbito agrario y forestal, pueda ser extendido en breve al conjunto de producciones, proporcionando un servicio cercano a productores, gestores e industrias agroalimentarias y forestales de la región.